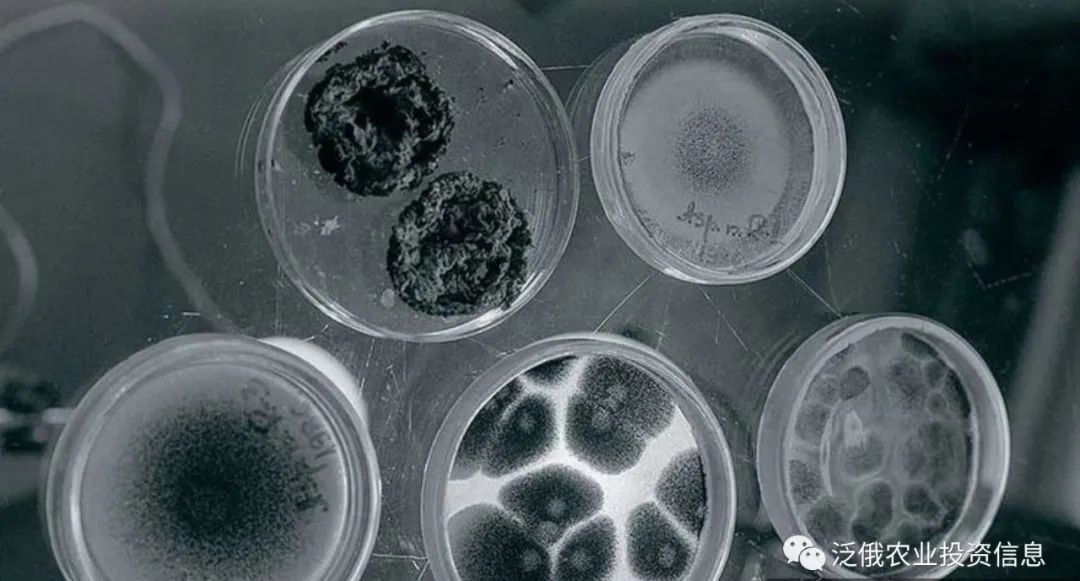
俄罗斯工业依赖进口,俄罗斯碳酸饮料现状

原创 夏尔 泛俄农业投资信息
由于受欧美制裁影响,俄罗斯食品和药品制造业原料供应中断问题越来越突出。主要涉及柠檬酸、乳酸,以及黄原胶等谷物深加产品。
今年9月份开始,俄罗斯已有三家农业巨头企业宣布将投资建设谷物深加工设施,生产此类产品。目前俄罗斯还不具备这方面的生产能力,虽然需求量很大,但100%依赖进口。大部分从中国进口、其次欧洲和印度。
如果这三个投资项目都能够成功落地,则俄罗斯不仅能够完全扭转同类产品依赖进口局面,还能对外出口。由于具备原料成本优势,俄罗斯未来有望成为柠檬酸、乳酸,以及黄原胶类产品主要出口国。
这些企业还打算进一步深化谷物加工设施,生产可降解生物材料。柠檬酸是可降解生物材料生产中的重要组成部分。可降解生物材料生产领域用途非常广泛。包括医药、服装、一次性餐具和包装等。 据了解,目前全球可降解生物餐具市场规模约为 30 亿美元,到2025年预计市场规模将增长到45亿美元。

01 俄罗斯最大淀粉出口商鲁斯塔克集团已启动柠檬酸、乳酸以及黄原胶生产投资项目。
在俄罗斯经营100多年的芬兰乳品公司 Valio,由于面临“前所未有的经济不确定性和地缘政治局势影响” 决定退出俄罗斯市场。
鲁斯塔克集团(«Рустарк»,原«Гулькевичский»淀粉厂)计划投资600亿卢布在俄罗斯小麦和玉米主产区南部地区和中央联邦区建设新的谷物深加工设施,生产柠檬酸、乳酸,以及黄原胶等产品。项目计划在克拉*诺斯**达尔工业技术园区和利佩茨克经济特区建设加工设施,在莫斯科的斯科尔科沃现代科技创新中心建立技术研究中心。
工厂预计2026年投产,建成后一年可加工100万吨玉米和70万小麦,食品和工业配料产品产量达到十万吨。其中,柠檬酸规划产能为8.5万吨/年。该产量能完全满足俄罗斯和独联体国家市场需求。
鲁斯塔克集团总经理说,考虑到这类产品在全球市场供应依然不完全充足,尤其欧洲、中东和非洲等地区,公司未来计划将柠檬酸产能再扩大一倍到20万吨,增加对外出口。
02 俄大型 化学品和塑料生产商Plant Space集团与鲁斯塔克集团竞争
在俄罗斯经营100多年的芬兰乳品公司 Valio,由于面临“前所未有的经济不确定性和地缘政治局势影响” 决定退出俄罗斯市场。
Plant Space( «Плант Спэйс»)计划2024 年底开始投资 190 亿卢布在中央联邦区的图拉州建设年产能为 7 万吨柠檬酸和 1 万吨乳酸的谷物深加工厂。项目计划在乌兹罗维亚经济特区落地。如果项目能够达产,不仅能完全覆盖俄罗斯市场,还能对外出口。
到今年年底,公司将完成厂房工程设计,2023年4月份到5月份期间开工建设。工厂包含将玉米深加工成葡萄糖的生产车间和将葡萄糖加工成柠檬酸、乳酸的独立生产车间。
03 西伯利亚农业集团公司Sibagro(«Сибагро»)在克拉*诺斯**亚尔斯克生产赖氨酸和可生物降解塑料
在俄罗斯经营100多年的芬兰乳品公司 Valio,由于面临“前所未有的经济不确定性和地缘政治局势影响” 决定退出俄罗斯市场。
除了鲁斯塔克集团和Plant Space集团,西伯利亚地区农业集团公司Sibagro(«Сибагро»)也于今年11月对外公布计划自2025年开始生产赖氨酸和可降解生物塑料。公司已经开始在克拉*诺斯**亚尔斯克边疆区投资建设谷物深加工厂,准备生产面筋、饲料蛋白浓缩物等。下一步增加赖氨酸和可降解生物塑料生产线。
项目计划投资额为294亿卢布,工厂满负荷生产后,加工规模可达到100 万吨,生物塑料年产量达到5万吨。

根据佳北农业行业部调研,两年前拥有 50 年历史的别尔哥罗德柠檬酸厂Citrobel( «Цитробел» 俄罗斯前农业土地储备排名第一的农业巨头Prodimex成员企业)作为全俄唯一一家有能力生产柠檬酸的企业,其柠檬酸年产量当时达到1.5万吨。但后来由于与政府产生分歧企业被迫停产。
关于在俄罗斯境内生产黄原胶类产品相关话题已经持续了至少15年。虽然有几家企业曾尝试生产,但由于研发投入巨大,生产工艺过于复杂,投资回收期太长等原因一直未能成功。
其他同类产品生产投资项目也由于资本密集度高和生产技术不成熟等原因未能实施。比如,Yarko-Lipetsk公司发起的有机酸加工厂建设项目已推迟数年,Technocord公司在奔萨地区规划的柠檬酸生产项目也长期被搁置。
俄罗斯NEO 农业咨询研究中心首席专家评论称,俄罗斯每年进口5.5万到6万吨的柠檬酸和0.8到1万吨的乳酸。这些产品及其衍生物在各个工业生产领域需求量很大。包括食品、药品、香水和化妆品等。
在此之前,俄罗斯以上产业基本由外资企业控制,所以柠檬酸和乳酸等原料也是通过这些企业境外供应渠道供应。这种产业结构成为俄罗斯酸类有机化学品本土化生产的最大障碍之一。
自俄乌冲突爆发以来,由于欧美对俄制裁,外资企业在俄罗斯境内的产业链出现断层,为这些一直被外资掌控的食品和工业配料产业本土化生产带来了巨大的机会。
信息来源:Agroinvector、EKCPERT、俄罗斯谷物信息网、农业市场研究所 ( NEO) 、佳北农业行研部